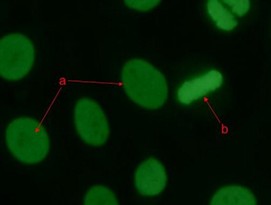
<p>Identify the antinuclear antibody (ANA) staining pattern in the image (a) and interpret what related disorder can be associated with this pattern? </p><p>A. Homogeneous or Diffused staining pattern; Systemic Lupus Erythematosus </p><p>B. Homogeneous or Diffused staining pattern; Scleroderma </p><p>C. Nucleolar staining pattern; Sjogren's syndrome </p><p>D. Peripheral or rim staining pattern; active Systemic Lupus Erythematosus</p>

1/233
Looks like no tags are added yet.
Name | Mastery | Learn | Test | Matching | Spaced |
|---|
No study sessions yet.
A patient’s specimen is strongly positive in an ANA ELISA. Which of the following would not be an appropriate follow up to this result?
A. Immunofluorescence test on HEp-2 cells
B. Specific ENA ELISA tests
C. Specific anti-DNA ELISA
D. Rheumatoid factor assay
D. Rheumatoid factor assay
High titers of antimicrosomal antibodies are most often found in:
A. rheumatoid arthritis
B. systemic lupus erythematosus
C. chronic hepatitis
D. thyroid disease
D. thyroid disease
Which laboratory finding is associated with multiple sclerosis?
A. Several bands on electrophoresis of cerebrospinal fluid
B. Antibody to thyroglobulin
C. Antibody to acetylcholine receptors
D. Presence of antinuclear antibodies
A. Several bands on electrophoresis of cerebrospinal fluid
Systemic lupus erythematosus can be distinguished from rheumatoid arthritis on the basis of which of the following?
A. Joint pain
B. Presence of inflammation
C. Deposition of immune complexes in the kidneys
D. Antibody to acetylcholine receptors
C. Deposition of immune complexes in the kidneys
Monoclonal antibodies are used in the treatment of some autoimmune diseases including Crohn's and rheumatoid arthritis. This therapeutic antibody reacts with
A. TGF-beta
B. TNF-alpha
C. IL-2
D. IL-6
B. TNF-alpha
Anti-CCP antibodies
A. are seen in all cases of rheumatoid arthritis and in people with chronic infections
B. are seen in about 70% of cases of rheumatoid arthritis and are rarely seen in others
C. are seen in all cases of rheumatoid arthritis and are rarely seen in others
D. are found only in patients with rheumatoid arthritis and patients with Lyme disease
B. are seen in about 70% of cases of rheumatoid arthritis and are rarely seen in others
Which of the following is correct regarding C-reactive protein (CRP)?
A. Is a highly specific test
B. Corresponds to serum complement levels
C. Is usually elevated in pediatric bacterial infections
D. Does not react with pneumococcal C-polysaccharide
C. Is usually elevated in pediatric bacterial infections
Dry eyes and mouth are symptoms of which of the following diseases?
A. scleroderma
B. myasthenia gravis
C. Sjögren's syndrome
D. systemic sclerosis
C. Sjögren's syndrome
Which of the following is decreased in serum during the active stages of systemic lupus erythematosus?
A. anti-nuclear antibody
B. immune complexes
C. complement (C3)
D. anti-DNA
C. complement (C3)
Which of the following is diagnostic for systemic lupus erythematosus?
A. Anti-Sm antibody
B. Anti-EB antibody
C. Anti-myelin basic protein antibody
D. Anti-insulin antibody
A. Anti-Sm antibody
Citrullinated proteins:
A. are modified by carbohydrate side chains.
B. contain modified (atypical) amino acids.
C. are denatured nucleic acids.
D. are microbial toxins.
B. contain modified (atypical) amino acids.
Antibodies to cyclic citrullinated peptides
A. recognize antigens that contain an arginyl converted to a cyclic citrullyl
B. have a high specificity for the diagnosis of SLE
C. have a high specificity for the diagnosis of autoimmune hepatitis
D. have a high specificity for the diagnosis of rheumatoid arthritis
E. A and D
E. A and D
A 35-year-old female experiences difficulty in walking, and her hands and feet are numb from time to time. Suspecting a disease involving the central nervous system, her physician orders magnetic resonance imaging (MRI). The MRI reveals lesions on the myelin sheath. What is the most likely disease?
A. Goodpasture's syndrome
B. Multiple myeloma
C. Graves disease
D. Multiple sclerosis
D. Multiple sclerosis
Autoimmunity
A. involves genetics
B. can sometimes be gender associated
C. can be hormone associated
D. B and C
E. all of the above
E. all of the above
A 56-year-old woman presents to her physician complaining of weight gain and joint problems. She is increasingly having difficulty walking up stairs and manipulating her fingers. Fingers in both hands as well as knees on both legs are equally painful and stiff. The symptoms have been getting progressively worse over the past 6 months. Rheumatoid factor is elevated, and antinuclear antibodies are not detected. Complement levels in her joints are decreased. This woman most likely has:
A. systemic lupus erythematosus.
B. Wegener's granulomatosis.
C. Hashimoto's thyroiditis.
D. rheumatoid arthritis.
D. rheumatoid arthritis.
In the rheumatoid factor test, what is being detected?
A. antinuclear antibody
B. antithyroglobulin antibody
C. IgM directed against IgG
D. IgG directed against IgM
C. IgM directed against IgG
Which of the following is used in rapid slide tests for detection of rheumatoid factors?
A. Whole IgM molecules
B. Fc portion of the IgG molecule
C. Fab portion of the IgG molecule
D. Fc portion of the IgM molecule
B. Fc portion of the IgG molecule
A 40-year-old female patient has increased thyroid-stimulating hormone (TSH) and decreased T4 levels with a normal T3 level. Antithyroglobulin is measured as 1:1280, and the antimicrosomal level is reportedly 1:6400. This patient most likely has:
A. type 1 diabetes.
B. Graves disease.
C. Hashimoto's thyroiditis.
D. systemic lupus erythematosus.
C. Hashimoto's thyroiditis.
Antibodies directed against thyroglobulin represent a significant finding in which of the following autoimmune diseases?
A. Myasthenia gravis
B. Multiple sclerosis
C. Hashimoto's thyroiditis
D. Contact dermatitis
C. Hashimoto's thyroiditis
Hashimoto’s thyroiditis can best be differentiated from Graves disease on the basis of which of the following?
A. Decrease in thyroid hormone levels
B. Presence of thyroid peroxidase antibodies
C. Enlargement of the thyroid
A. Decrease in thyroid hormone levels
Rheumatoid factors are defined as:
A. antigens found in the sera of patients with rheumatoid arthritis
B. identical to the rheumatoid arthritis precipitin
C. autoantibodies with specificity for the Fc portion of the immunoglobulin (IgG) molecule
D. Capable of forming circulating immune complexes only when IgM-type autoantibody is present
C. autoantibodies with specificity for the Fc portion of the immunoglobulin (IgG) molecule
IgA autoantibodies against gliadin, tissue transglutaminase, and endomysium are found in patients which of the following diseases?
A. celiac
B. Crohn's
C. type 1 diabetes mellitus
D. Addison's
A. celiac disease
Antibody to which of the following cytokines can be used to treat rheumatoid arthritis.
A. IL2
B. GM-CSF
C. TGF-beta
D. TNF-alpha
D. TNF-alpha
Antinuclear antibody tests are performed to help diagnose:
A. acute leukemia
B. lupus erythematosus
C. hemolytic anemia
D. Crohn’s disease
B. systemic lupus erythematosus
A 45-year-old male presents to his physician complaining of achy joints, chronic runny nose, and coughing up blood. Chest x-ray shows pulmonary infiltrates. Cortisol is increased; erythrocyte sedimentation rate (ESR) is slightly elevated. Tests for autoantibodies are positive for antineutrophil cytoplasmic antibodies. On the basis of these findings, a likely diagnosis for this patient is:
A. systemic lupus erythematosus.
B. rheumatoid arthritis.
C. chronic granulomatous disease.
D. Wegener's granulomatosis (Granulomatosis with polyangiitis-GPA)
D. Wegener's granulomatosis (Granulomatosis with polyangiitis-GPA)
Screening and confirmation tests for antinuclear antibodies are typically performed by:
A. immunodiffusion followed by indirect immunofluorescence.
B. indirect immunofluorescence followed by enzyme immunoassay.
C. direct immunofluorescence followed by serum protein electrophoresis.
D. immunofixation electrophoresis followed by direct immunofluorescence.
B. indirect immunofluorescence followed by enzyme immunoassay.
Another student has an odd-looking blistery rash and has been losing weight. You and she are good friends, but must she tell you about her bowel symptoms? She has diarrhea and cramping. What do you think she might have?
A. Grave's disease
B. Hashimoto's disease
C. Addison's disease
D. Celiac disease
D. Celiac Disease
A patient comes into the clinic with dry eyes and dry mouth but no joint pain. What diagnosis would you expect?
A. SLE
B. rheumatoid factor
C. Crohn's disease
D. celiac disease
E. Sjögren’s syndrome
E. Sjögren’s syndrome
Tissue injury in systemic rheumatic disorders such as systemic lupus erythematosus is thought to be caused by:
A. cytotoxic T cells
B. IgE activity
C. deposition of immune complexes
D. cytolytic antibodies
C. deposition of immune complexes
A patient comes into the clinic with dry eyes and dry mouth but no joint pain. Which pattern of ANA staining would you expect?
Aperipheral
nucleolar
Correct:
speckled
Correct answer
homogeneous
In antinuclear antibody testing, HEp-2 cells:
A. are the source of the antigen.
B. are the source of the antibody.
C. are fluorescently labeled.
D. fluoresce spontaneously.
A. are the source of the antigen
ANCA is found in
A. type 1 diabetes
B. Hashimoto's disease
C. SLE
D. Wegener's granulomatosis
D. Wegener's granulomatosis
ANCA
A. stands for antinuclear and cytoplasmic antibodies
B. stands for antineutrophil and cytoplasmic antigens
C. aids in the diagnosis of vasculitic diseases
D. A and C
E. B and C
D. A and C
Antibodies to cyclic citrullinated proteins (anti-CCP) are specific diagnostic indicators for:
A. type 1 diabetes mellitus.
B. celiac disease.
C. rheumatoid arthritis.
D. biliary cirrhosis.
C. rheumatoid arthritis
An antinuclear antibody test is performed on a specimen from a 55-year-old woman who has unexplained joint pain. The IFA result is a titer of 40 and a homogeneous pattern. The appropriate follow-up for this patient is:
A. Anti-DNA assay
B. Extractable nuclear antigen (ENA) testing
C. Retest ANA in 3–6 months
D. CH50 complement assay
C. Retest ANA in 3–6 months.
A student in the class always is complaining that she's cold, she's tired, she's been gaining weight but says she just doesn't care about anything anymore. The semester has been tough, and although you feel guilty, at first you ignore her, but just now as you looked up, her neck appears to be enlarged in the front and her skin and hair look dry. What do you think she might have?
A. Grave's disease
B. Hashimoto's disease
C. Addison's disease
D. Celiac disease
B. Hashimoto's disease
Serum from CREST subset of systemic sclerosis in ANA testing shows
A. centromere staining
B. speckled staining
C. rim staining
D. homogeneous staining
A. centromere staining
A speckled nuclear pattern in an antinuclear antibody test indicates:
A. anti-RNA antibody.
B. antibody to DNA-histone complex.
C. anticentromere antibody.
D. antibody to an extractable nuclear antigen.
D. antibody to an extractable nuclear antigen.
An autoimmune disease-causing destruction of pancreatic cells can result in
A. Hashimoto disease
B. multiple sclerosis
C. myasthenia gravis
D. type 1 diabetes
D. type 1 diabetes
A positive ANA with the pattern of anticentromere antibodies is most frequently seen in patients with:
A. rheumatoid arthritis
B. systemic lupus erythematosus
C. CREST syndrome
D. Sjӧgren syndrome
C. CREST syndrome
Raynaud's phenomenon is associated with a deficiency/dysfunction of the complement fraction
A. C2
B. C5
C. C7
D. C8
C. C7
A 16-year-old male goes to his physician for an annual checkup. A routine urinalysis indicates the presence of blood, an increase in protein, and an increase in urea. The young man reports that he has been feeling tired and has a persistent cough. The doctor orders additional laboratory testing, including a serum test for rheumatoid factor, antinuclear antibody testing, anti-streptolysin O testing, and testing for the presence of anti–basement membrane antibodies. Only the latter test was positive. What disease is the most likely cause of the symptoms?
A. Systemic lupus erythematosus
B. Goodpasture's syndrome
C. Multiple sclerosis
D. Rheumatoid arthritis
B. Goodpasture's syndrome
SLE is
A. related to a single gene mutation
B. made worse by exposure to sunlight
C. due to inflammation caused by circulating immune complexes
D. B and C
E. all of the above
D. B and C
In the indirect fluorescent anti-nuclear antibody test, a homogenous pattern indicates the presence of antibody to:
A. RNP
B. Sm
C. RNA
D. DNA
D. DNA
In an anti-nuclear antibody indirect immunofluorescence test, a sample of patient serum shows a positive, speckled pattern. Which would be the most appropriate additional test to perform?
A. anti-mitochondrial antibody
B. immunoglobulin quantitation
C. screen for Sm and RNP antibodies
D. anti-DNA antibody using Crithidia luciliae
C. screen for Sm and RNP antibodies
The characteristic antinuclear antibody pattern produced by antibody to DNA-histone complexes is:
A. homogeneous.
B. peripheral.
C. speckled.
D. nucleolar.
A. homogeneous.
Which of the following is considered a systemic autoimmune disease?
A. Multiple sclerosis
B. Graves disease
C. Myasthenia gravis
D. Systemic lupus erythematosus
D. Systemic lupus erythematosus
The "CREST" variant of which disease is associated with the presence of an anticentromere antibody?
A. Progressive systemic sclerosis (scleroderma)
B. Rheumatoid arthritis
C. Systemic lupus erythematosus
D. Mixed connective tissue disease
A. Progressive systemic sclerosis (scleroderma)
Autoimmunity can be
A. infection associated because of a cross-reactive epitope
B. environmentally associated
C. trauma associated
D. A and B
E. all of the above
E. all of the above
Antibodies directed at native DNA are most frequently associated with which pattern of fluorescence in the IFA-ANA test?
A. rim
B. diffuse
C. Speckled
D. centromere
A. rim
Anti-RNA antibodies are often present in individuals having an anti-nuclear antibody immunofluorescent pattern that is:
A. speckled
B. rim
C. diffuse
D. nucleolar
D. nucleolar
The characteristics of an acute phase protein include the following EXCEPT:
A. An acute phase response is a non-specific indicator of an inflammatory response
B. Acute phase proteins are synthesized slowly in response to tissue injury.
C. C-reactive protein is an acute phase protein.
D. Laboratory measurement of an acute phase can be used to monitor the progress of therapy in inflammatory diseases
B. Acute phase proteins are synthesized slowly in response to tissue injury.
An autoimmune disease characterized by pain and progressive destruction of the joints, weight loss, morning stiffness, and presence of an antibody directed against IgG best describes:
A. rheumatoid arthritis.
B. lupus.
C. hemolytic disease of the newborn.
D. hemolytic anemia
A. rheumatoid arthritis.
Rheumatoid factor reacts with:
A. inert substances such as latex
B. Rh-pos erythrocytes
C. kinetoplasts of Crithidia luciliae
D. gamma globulin-coated particles
D. gamma globulin-coated particles
Sera to be tested for IFA-ANA 6 days after drawing is best stored at?
A. room temperature
B. 5°C +/- 2°
C. -70°C in a constant temperature freezer
D. -20°C in a frost-free self-defrosting freezer
B. 5°C +/- 2°
What disease is indicated by a high titer of anti-Sm (anti-Smith) antibody?
A. Mixed connective tissue disease (MCTD)
B. RA
C. SLE
D. Scleroderma
C. SLE
Systemic lupus erythematosus is characterized by:
A. HLA-DR antigens expressed on thyroid epithelial cells.
B. increase in cells lining the synovial membrane.
C. absence of immune complexes.
D. presence of dsDNA antibodies
D. presence of dsDNA antibodies
What is a general definition for autoimmunity?
A. Increase of tolerance to self-antigens
B. Loss of tolerance to self-antigens
C. Increase in clonal deletion of mutant cells
D. Manifestation of immunosuppression
B. Loss of tolerance to self-antigens
For the diagnosis of Systemic Lupus Erythematosus (SLE) which of the following test principles provides the highest specificity?
A. FANA
B. ELISA
C. Latex ANA
D. CRP
B. ELISA
Which autoimmune disorder is characterized by a homogenous pattern in animmunofluorescence (IF) microscopy test for anti-nuclear antibodies (ANAs)?
A. Sjogren's syndrome
B. CREST syndrome
C. Systemic Lupus Erythematosus (SLE)
D. Scleroderma
C. Systemic Lupus Erythematosus (SLE)
When a Speckled Nuclear Antibody (ANA) pattern is observed, what follow-up test for antibodies related to Systemic Lupus Erythematosus (SLE) is not beneficial?
A. Testing for antibodies to Smith (Sm)
B. Testing for all antibodies to the extractable nuclear antigens (ENA)
C. Testing for antibodies to SS-A/SS-B+
D. Testing for antibodies to U1RNP+ and dcSSc
D. Testing for antibodies to U1RNP+ and dcSSc
Which of the following autoantibodies are found in a patient with Hashimoto thyroiditis?
A. Thyroid-stimulating hormone receptor antibodies (TRAbs)
B. Antithyroid peroxidase (TPO)
C. Islet cell antibodies
D. Antitransglutaminase (tTG)
B. Antithyroid peroxidase (TPO)

Identify the anti-nuclear antibody (ANA) pattern in this microscopic image.
A. Homogeneous
B. Speckled
C. Anticentromere antibody
D. Anti-Ro (SS-A) (alcohol fixation)
B. Speckled

This antinuclear antibody (ANA) pattern is characterized by granular staining in the nuclei of the interphase cells (a). There is also an absence of staining in the chromosomal area of the metaphase mitotic cells (b). The slide is viewed using fluorescent microscopy.
A. Homogeneous
B. Speckled
C. Nucleolar
D. Centromere
B. Speckled
Identify the antinuclear antibody (ANA) staining pattern in the image (a) and interpret what related disorder can be associated with this pattern?
A. Homogeneous or Diffused staining pattern; Systemic Lupus Erythematosus
B. Homogeneous or Diffused staining pattern; Scleroderma
C. Nucleolar staining pattern; Sjogren's syndrome
D. Peripheral or rim staining pattern; active Systemic Lupus Erythematosus
A. Homogeneous or Diffused staining pattern; Systemic Lupus Erythematosus

What antinuclear antibody (ANA) staining pattern is demonstrated in this microscopic, fluorescent test image?
A. Homogeneous
B. Speckled
C. Nucleolar
D. Centromere
D. Centromere